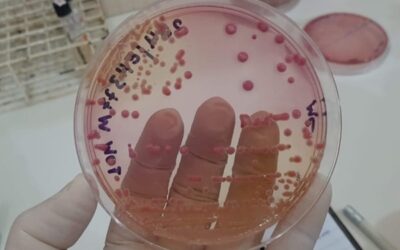
Fiocruz e Cepen investigam RAM de bactérias Klebsiella e Pseudomonas aeruginosa

Casos recentes envolvendo hantavírus e suspeitas de contaminação bacteriana em produtos de consumo voltaram a chamar atenção para um tema que...
LEIA MAISFINEP abre Seleção Pública para financiamento de desenvolvimento de produtos ou processos inovadores para empresas nas áreas de saúde e fármacos
por CBDL Diagnóstico para a Vida | 20 fev, 2026 | Notícias, Pesquisa
A FINEP (Financiadora de Estudos e Projetos), empresa pública vinculada ao Ministério da Ciência, Tecnologia e Inovação (MCTI) promove uma...
LEIA MAISFinep lança novo ciclo do Inovacred com R$ 1 bilhão para financiar projetos de inovação
por CBDL Diagnóstico para a Vida | 3 nov, 2025 | Notícias, Pesquisa
A partir de 3 de novembro de 2025, empresas de todo o país poderão apresentar propostas de projetos de inovação para concorrer a recursos do...
LEIA MAISMédicos Sem Fronteiras celebra avanços no desenvolvimento de vacina nacional de mRNA pela Fiocruz
por CBDL Diagnóstico para a Vida | 26 ago, 2025 | Notícias, Pesquisa
A organização humanitária internacional Médicos Sem Fronteiras considera que o desenvolvimento e patenteamento de uma plataforma nacional para...
LEIA MAISVacina de RNA Mensageiro aponta para imunização universal contra o câncer
por CBDL Diagnóstico para a Vida | 29 jul, 2025 | Novidades, Pesquisa
Uma nova vacina experimental, baseada em RNA mensageiro (mRNA), pode representar um marco na luta contra o câncer. Desenvolvida por...
LEIA MAISDispositivo criado por brasileiro avança no diagnóstico de infarto
por CBDL Diagnóstico para a Vida | 24 jul, 2025 | Novidades, Pesquisa
Um dispositivo físico com um software que interpreta o resultado do exame de sangue em conjunto com os dados clínicos do paciente. Essa...
LEIA MAISFiocruz e Cepen investigam RAM de bactérias Klebsiella e Pseudomonas aeruginosa
por CBDL Diagnóstico para a Vida | 15 jul, 2025 | Pesquisa
Pesquisadores da Fiocruz e do Centro de Pesquisa em Medicina Tropical (Cepem) de Rondônia identificaram espécies bacterianas e investigaram o...
LEIA MAIS“Um novo olhar sob a pesquisa clínica”: livro destaca a importância de rigorosos padrões éticos e regulatórios nas pesquisas com seres humanos
por CBDL Diagnóstico para a Vida | 2 out, 2024 | Novidades, Pesquisa
Coordenadora do Centro Mater Dei de Ensino, Pesquisa e Inovação conta em sua obra os bastidores da ciência e reforça o compromisso com a...
LEIA MAISHospitais brasileiros registram aumento de bactéria super-resistente após pandemia de Covid-19
por CBDL Diagnóstico para a Vida | 7 ago, 2024 | Pesquisa
Um estudo liderado pela pesquisadora Jussimara Monteiro, gerente do Núcleo de Apoio ao Serviço de Controle de Infecção Hospitalar (NASCIH) da...
LEIA MAISOMS e FIND firmam acordo para acesso e aceleração de tecnologias para diagnósticos
por CBDL Diagnóstico para a Vida | 10 jun, 2024 | Novidades, Pesquisa, Política, Tecnologia
A Organização Mundial da Saúde (OMS) e a instituição internacional de diagnóstico, FIND, assinaram, na última terça-feira (4/6), um acordo de...
LEIA MAISCPDI IBRACHINA/IBRAWORK E UNICAMP LANÇAM EDITAL OPEN INNOVATION DE SAÚDE. EDITAL É VOLTADO PARA PROJETOS DE INOVAÇÃO EM DIVERSAS ÁREAS DA SAÚDE HUMANA
por CBDL Diagnóstico para a Vida | 2 abr, 2024 | Novidades, Pesquisa
O Centro de Pesquisa, Desenvolvimento e Inovação (CPDI) Ibrachina/Ibrawork e a Unicamp lançaram o edital Open Innovation na Saúde, voltado para...
LEIA MAISInovação em Diagnóstico foi tema de apresentação durante seminário da CBDL
por CBDL Diagnóstico para a Vida | 19 mar, 2024 | CBDL, Pesquisa, Tecnologia
A diretora técnica e farmacêutica Josely Chiarella participou do seminário “As Perspectivas para Inovação em Diagnóstico no Brasil”, encontro...
LEIA MAISÚltimas postagens
- Pague Menos e Merck disponibilizam mais de 1 milhão de exames gratuitos para detecção precoce do pré-diabetes
- CBDL visita unidade da Beckman Coulter em Santa Catarina
- Médicos Sem Fronteiras reforça preparação para emergências no Brasil com treinamento conjunto com a Força Nacional do SUS
Categorias
Nuvem de tags
#ans #bioMérieux #DNA #RAM #sus abiis adlm ADLM 2026 Anvisa Arthur Mancini CBDL congresso Diagnósticos Inovadores para Terapias Avançadas doenças Einstein exames fórum Fórum Nacional em Triagem Neonatal SBTEIM hospitalar hospitalar 2026 IA IMDRF informação para prevenção inteligência artificial Laboratorial LIS Medicina laboratorial medtech MedTech europe oms opas política postagem de teste Resistência aos Antimicrobianos. Saude SBPC/ML SBTEIM Seegene Tecnologia Terapias Avançadas teste do pezinho Thermo Fisher Scientific Triagem Neonatal VII CONGIPLAB XI Fórum ABIIS